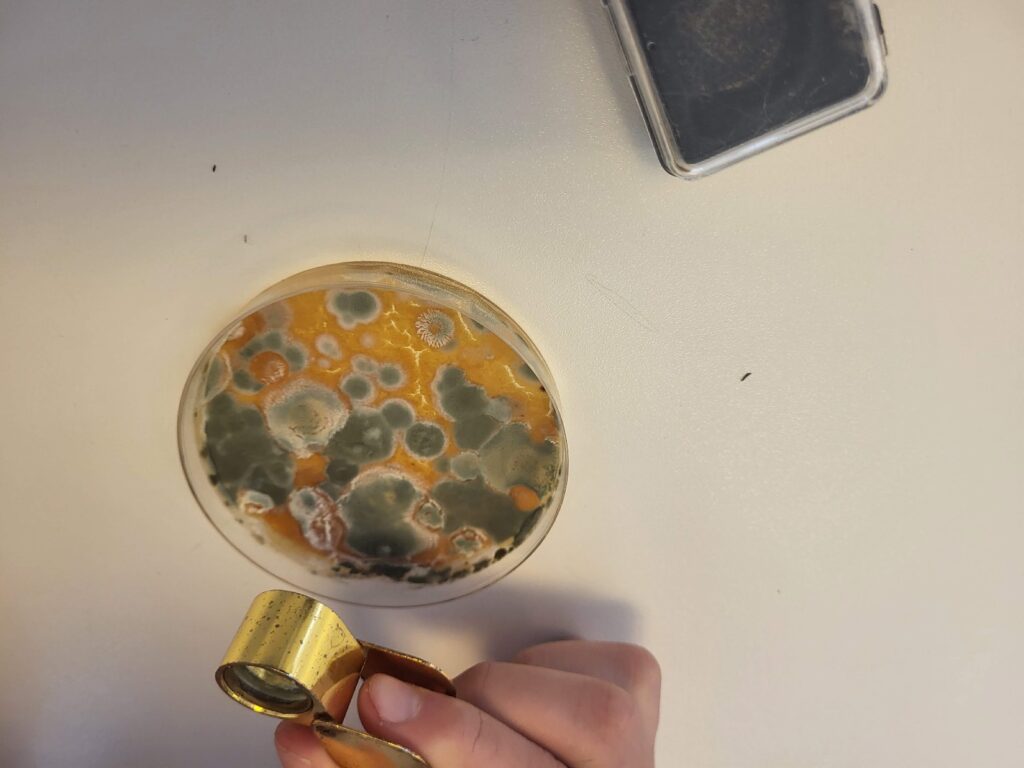

Os alunos do 6.º ano de Ciências Naturais efetuaram uma atividade onde puderam observar microrganismos em ação. Em placas de Petri com um meio nutritivo fizeram-se multiplicar bactérias retiradas da superfície do nosso corpo e aguardam-se resultados. Mas previamente, com condições ideais de humidade e temperatura, foi possível fazer crescer fungos para observar durante a aula.







